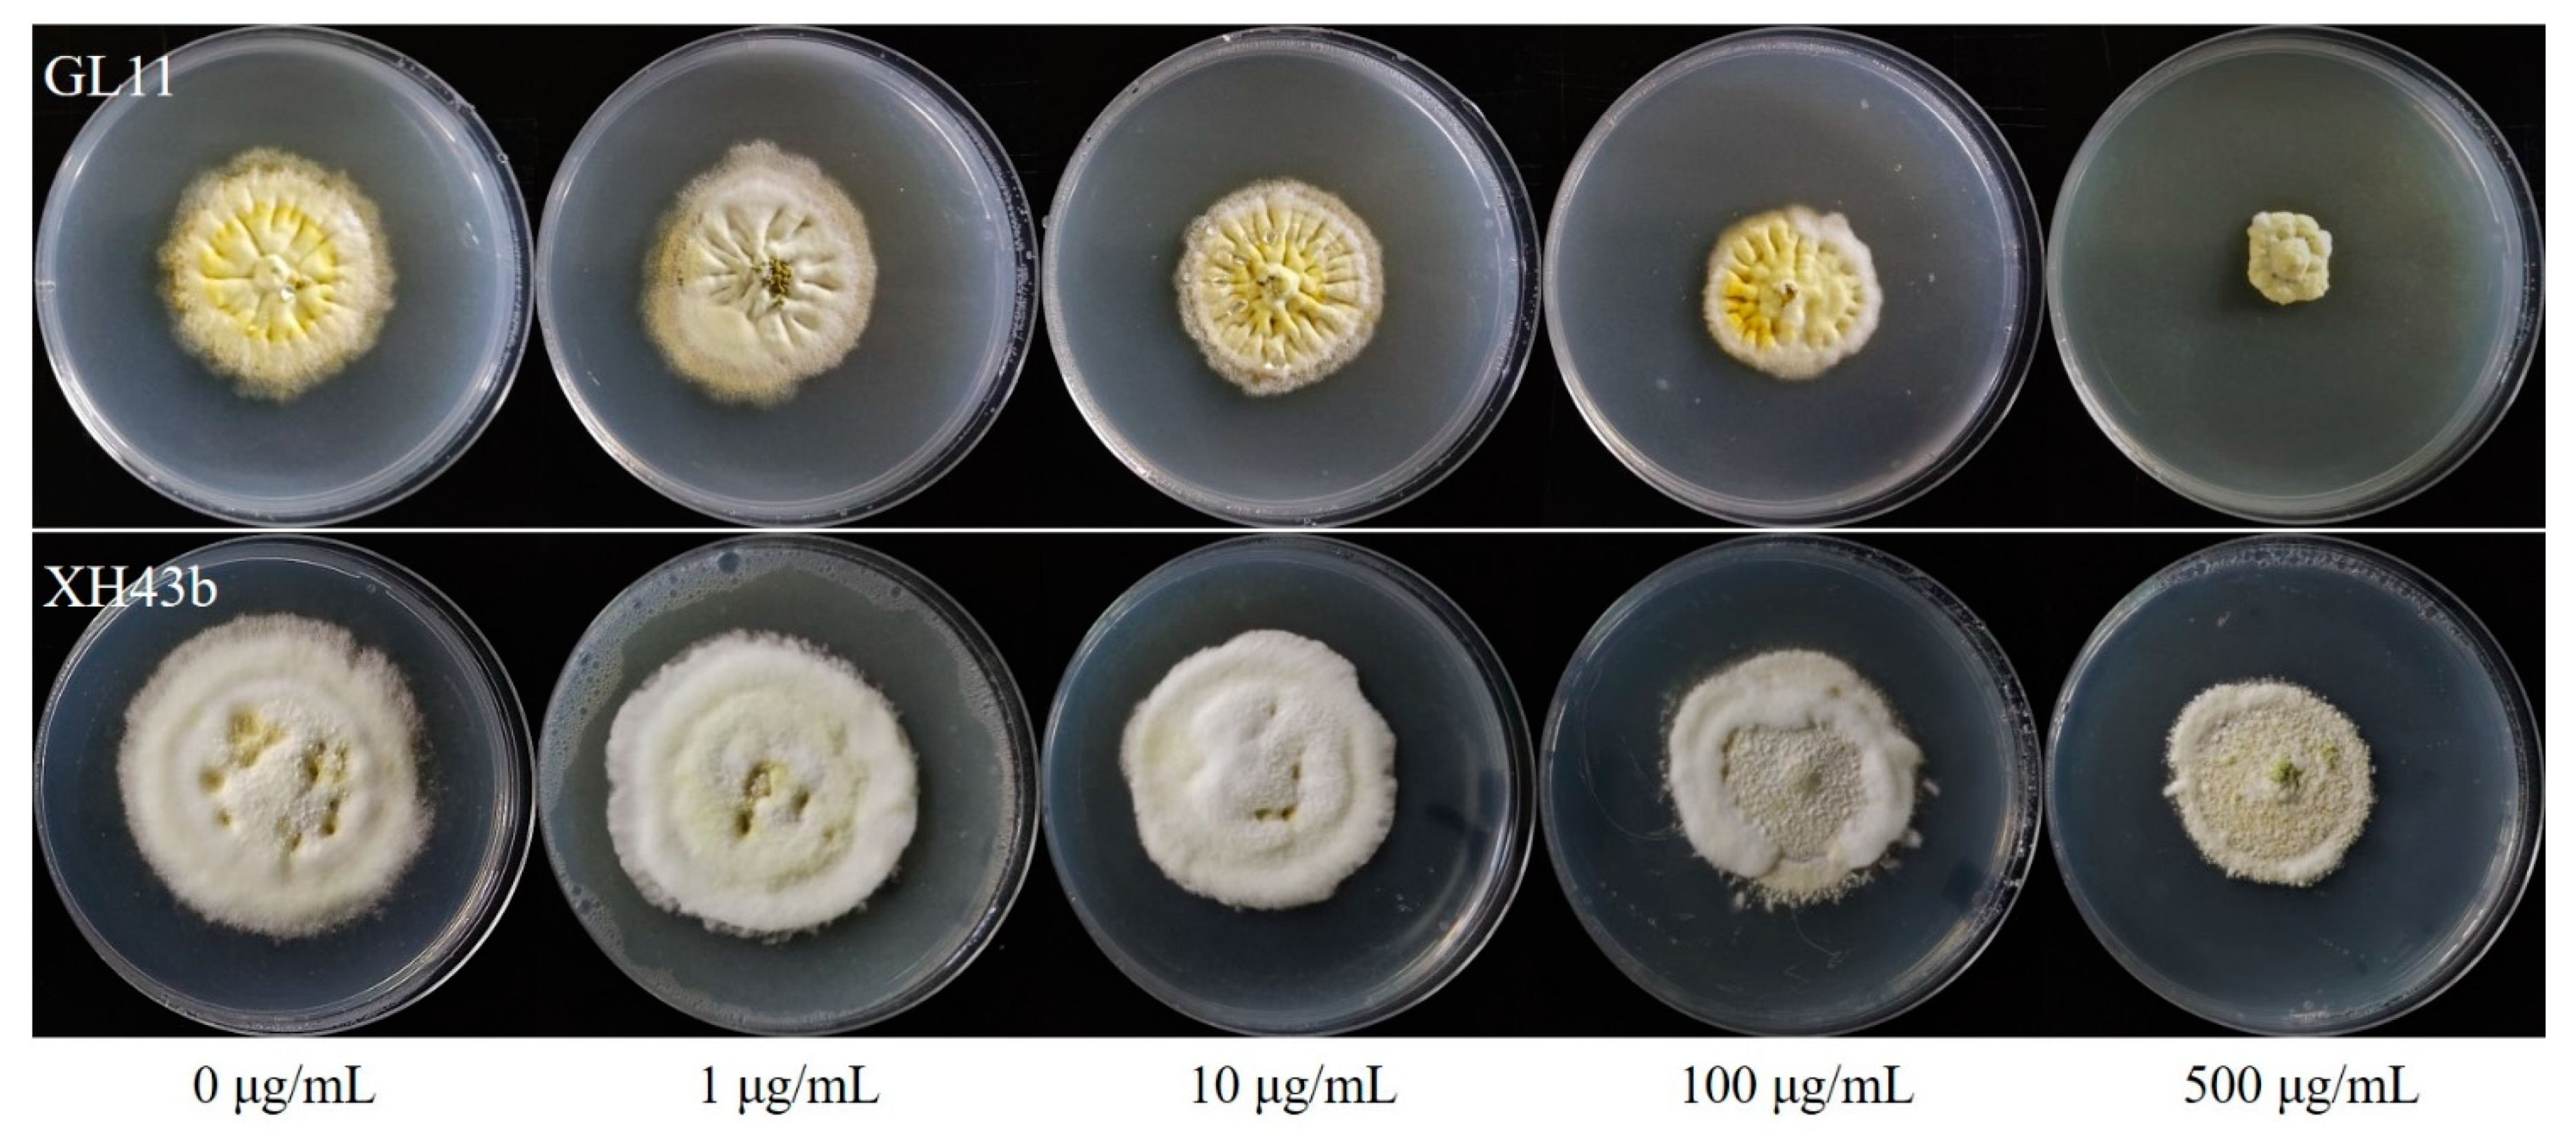
Jof 08 01311 g004 Jof 08 01311 g004

Prevalence of Carbendazin Resistance in Field Populations of the Rice False Smut Pathogen Ustilaginoidea virens from Jiangsu, China, Molecular Mechanisms, and Fitness Stability
Abstract
1. Introduction
2. Materials and Methods
2.1. Isolation
2.2. Fungicides and Medium
2.3. In Vitro Sensitivity Determination of U. virens to Carbendazim
2.4. Investigation of Mycelial Growth, Mycelial Dry Weight, Conidiation, and Conidial Germination Rate In Vitro
2.5. Stability of Resistant to Carbendazim
2.6. Correlation Analysis in Sensitivity of Carbendazim with Diethofencarb, Azoxystrobin, Pyraclostrobin, and Tebuconazole
2.7. Cloning and Sequence Analysis
2.8. Phylogenetic Analysis
2.9. Data Analysis
3. Results
3.1. Sensitivity of the Field Isolates to Carbendazim
3.2. Fitness and Stability of Resistant Isolates
3.3. Correlation in Sensitivity of Carbendazim to Diethofencarb, Azoxystrobin, Pyraclostrobin, and Tebuconazole
3.4. Nucleotide Sequence Analysis of the β-Tubulin Genes
3.5. Phylogenetic Analyses of Predicted Amino Acid Sequences
4. Discussion
Supplementary Materials
Author Contributions
Funding
Institutional Review Board Statement
Informed Consent Statement
Data Availability Statement
Conflicts of Interest
References
- Sun, W.X.; Fan, J.; Fang, A.F.; Li, Y.J.; Tariqjaveed, M.; Li, D.Y.; Hu, D.W.; Wang, W.M. Ustilaginoidea virens: Insights into an emerging rice pathogen. Annu. Rev. Phytopathol. 2020, 58, 363–385. [Google Scholar] [CrossRef] [PubMed]
- Tanaka, E.; Ashizawa, T.; Sonoda, R.; Tanaka, C. Villosiclava virens gen. nov., comb. nov., teleomorph of Ustilaginoidea virens, the causal agent of rice false smut. Mycotaxon 2008, 106, 491–501. [Google Scholar]
- Fan, J.; Yang, J.; Wang, Y.; Li, G.; Li, Y.; Huang, F.; Wang, W. Current understanding on Villosiclava virens, a unique flower-infecting fungus causing rice false smut disease. Mol. Plant Pathol. 2016, 17, 1321–1330. [Google Scholar] [CrossRef] [PubMed]
- Koiso, Y.; Li, Y.; Iwasaki, S.; Hanaoka, K.; Kobayashi, T.; Sonoda, R.; Fujita, Y.; Yaegashi, H.; Sato, Z. Ustiloxins, antimitotic cyclic-peptides from false smut balls on rice panicles caused by Ustilaginoidea virens. J. Antibiot. 1994, 47, 765–773. [Google Scholar] [CrossRef] [PubMed]
- Hu, Z.; Dang, Y.; Liu, C.; Zhou, L.; Liu, H. Acute exposure to ustiloxin A affects growth and development of early life zebrafish, Danio rerio. Chemosphere 2019, 226, 851–857. [Google Scholar] [CrossRef] [PubMed]
- Chen, Y.; Zhang, Y.; Yao, J.; Li, Y.F.; Yang, X.; Wang, W.X.; Zhang, A.F.; Gao, T.C. Frequency distribution of sensitivity of Ustilaginoidea virens to four EBI fungicides, prochloraz, difenoconazole, propiconazole and tebuconazole, and their efficacy in controlling rice false smut in Anhui Province of China. Phytoparasitica 2013, 41, 277–284. [Google Scholar] [CrossRef]
- Tang, Y.X.; Jin, J.; Hu, D.W.; Yong, M.L.; Xu, Y.; He, L.P. Elucidation of the infection process of Ustilaginoidea virens (teleomorph: Villosiclava virens) in rice spikelets. Plant Pathol. 2013, 62, 1–8. [Google Scholar] [CrossRef]
- Song, J.H.; Wei, W.; Lv, B.; Lin, Y.; Yin, W.X.; Peng, Y.L.; Schnabel, G.; Huang, J.B.; Jiang, D.H.; Luo, C.X. Rice false smut fungus hijacks the rice nutrients supply by blocking and mimicking the fertilization of rice ovary. Environ. Microbiol. 2016, 18, 3840–3849. [Google Scholar] [CrossRef]
- Wang, F.; Lin, Y.; Yin, W.X.; Peng, Y.L.; Schnabel, G.; Huang, J.B.; Luo, C.X. The Y137H mutation of VvCYP51 gene confers the reduced sensitivity to tebuconazole in Villosiclava virens. Sci. Rep. 2015, 5, 17575. [Google Scholar] [CrossRef]
- Shi, N.-N.; Ruan, H.-C.; Chen, F.-R.; Zhang, Y.-L.; Yang, X.-J.; Dai, Y.-L.; Gan, L.; Du, Y.-X. Development and application of an allele-specific PCR assay for detecting T409C mutation of cyp51 gene linked with tebuconazole resistance in Villosiclava virens (rice false smut). Can. J. Plant Pathol. 2017, 39, 318–324. [Google Scholar] [CrossRef]
- Zhou, Y.; Yu, J.; Pan, X.; Yu, M.; Du, Y.; Qi, Z.; Zhang, R.; Song, T.; Yin, X.; Liu, Y. Characterization of propiconazole field-resistant isolates of Ustilaginoidea virens. Pestic. Biochem. Physiol. 2019, 153, 144–151. [Google Scholar] [CrossRef] [PubMed]
- Song, J.-H.; Zhang, S.-J.; Wang, Y.; Chen, Y.-T.; Luo, J.-F.; Liang, Y.; Zhang, H.-C.; Dai, Q.-G.; Xu, K.; Huo, Z.-Y. Baseline sensitivity and control efficacy of two quinone outside inhibitor fungicides, azoxystrobin and pyraclostrobin, against Ustilaginoidea virens. Plant Dis. 2022, 106, 2967–2973. [Google Scholar] [CrossRef] [PubMed]
- FRAC. FRAC Code List 2022: Fungal Control Agents Sorted by Cross-Resistance Pattern and Mode of Action. 2022. Available online: https://www.frac.info/docs/default-source/publications/frac-code-list/frac-code-list-2022--final.pdf?sfvrsn=b6024e9a_2 (accessed on 16 December 2022).
- Bollen, G.J.; Scholten, G. Acquired resistance to benomyl and some other systemic fungicides in a strain of Botrytis cinerea in cyclamen. Neth. J. Plant Pathol. 1971, 77, 83–90. [Google Scholar] [CrossRef]
- Koenraadt, H.; Somerville, S.C.; Jones, A.L. Characterization of mutations in the beta-tubulin gene of benomyl-resistant field strains of Venturia inaequalis and other plant pathogenic fungi. Phytopathology 1992, 82, 1348–1354. [Google Scholar] [CrossRef]
- Albertini, C.; Gredt, M.; Leroux, P. Mutations of the beta-tubulin gene associated with different phenotypes of benzimidazole resistance in the cereal eyespot fungi Tapesia yallundae and Tapesia acuformis. Pestic. Biochem. Physiol. 1999, 64, 17–31. [Google Scholar] [CrossRef]
- Leroux, P.; Fritz, R.; Debieu, D.; Albertini, C.; Lanen, C.; Bach, J.; Gredt, M.; Chapeland, F. Mechanisms of resistance to fungicides in field strains of Botrytis cinerea. Pest Manage. Sci. 2002, 58, 876–888. [Google Scholar] [CrossRef]
- Ma, Z.H.; Michailides, T.J. Advances in understanding molecular mechanisms of fungicide resistance and molecular detection of resistant genotypes in phytopathogenic fungi. Crop Prot. 2005, 24, 853–863. [Google Scholar] [CrossRef]
- Friedrich, K.; da Silveira, G.R.; Amazonas, J.C.; Gurgel, A.D.; de Almeida, V.E.S.; Sarpa, M. International regulatory situation of pesticides authorized for use in Brazil: Potential for damage to health and environmental impacts. Cad. Saude Publica 2021, 37, e00061820. [Google Scholar] [CrossRef]
- Song, J.; Wang, Z.; Zhang, S.; Wang, Y.; Liang, Y.; Dai, Q.; Huo, Z.; Xu, K. The toxicity of salicylhydroxamic acid and its effect on the sensitivity of Ustilaginoidea virens to azoxystrobin and pyraclostrobin. J. Fungi 2022, 8, 1231. [Google Scholar] [CrossRef]
- Hawkins, N.J.; Fraaije, B.A. Predicting resistance by mutagenesis: Lessons from 45 years of MBC resistance. Front. Microbiol. 2016, 7, 1814. [Google Scholar] [CrossRef]
- Yan, K.; Dickman, M.B. Isolation of a beta-tubulin gene from Fusarium moniliforme that confers cold-sensitive benomyl resistance. Appl. Environ. Microbiol. 1996, 62, 3053–3056. [Google Scholar] [CrossRef] [PubMed]
- Chen, Z.H.; Gao, T.; Liang, S.P.; Liu, K.X.; Zhou, M.G.; Chen, C.J. Molecular mechanism of resistance of Fusarium fujikuroi to benzimidazole fungicides. FEMS Microbiol. Lett. 2014, 357, 77–84. [Google Scholar] [CrossRef] [PubMed]
- Kumar, S.; Stecher, G.; Li, M.; Knyaz, C.; Tamura, K. MEGA X: Molecular evolutionary genetics analysis across computing platforms. Mol. Biol. Evol. 2018, 35, 1547–1549. [Google Scholar] [CrossRef]
- Liu, X.; Yin, Y.N.; Wu, J.B.; Jiang, J.H.; Ma, Z.H. Identification and characterization of carbendazim-resistant isolates of Gibberella zeae. Plant Dis. 2010, 94, 1137–1142. [Google Scholar] [CrossRef] [PubMed]
- Xu, S.Q.; Wang, J.H.; Wang, H.X.; Bao, Y.X.; Li, Y.S.; Govindaraju, M.; Yao, W.; Chen, B.S.; Zhang, M.Q. Molecular characterization of carbendazim resistance of Fusarium species complex that causes sugarcane pokkah boeng disease. BMC Genom. 2019, 20, 115. [Google Scholar] [CrossRef]
- Oliveira, T.Y.K.; Silva, T.C.; Moreira, S.I.; Christiano, F.S., Jr.; Gasparoto, M.C.G.; Fraaije, B.A.; Ceresini, P.C. Evidence of resistance to QoI fungicides in contemporary populations of Mycosphaerella fijiensis, M. musicola and M. thailandica from banana plantations in southeastern Brazil. Agronomy 2022, 12, 2952. [Google Scholar] [CrossRef]
- Yarden, O.; Katan, T. Mutations leading to substitutions at amino acids 198 and 200 of beta-tubulin that correlate with benomyl-resistance phenotypes of field strains of Botrytis cinerea. Phytopathology 1993, 83, 1478–1483. [Google Scholar] [CrossRef]
- Banno, S.; Fukumori, F.; Ichiishi, A.; Okada, K.; Uekusa, H.; Kimura, M.; Fujimura, M. Genotyping of benzimidazole-resistant and dicarboximide-resistant mutations in Botrytis cinerea using real-time polymerase chain reaction assays. Phytopathology 2008, 98, 397–404. [Google Scholar] [CrossRef]
- Katan, T.; Elad, Y.; Yunis, H. Resistance to diethofencarb (NPC) in benomyl-resistant field isolates of Botrytis cinerea. Plant Pathol. 1989, 38, 86–92. [Google Scholar] [CrossRef]
- Leroux, P.; Chapeland, F.; Desbrosses, D.; Gredt, M. Patterns of cross-resistance to fungicides in Botryotinia fuckeliana (Botrytis cinerea) isolates from French vineyards. Crop Prot. 1999, 18, 687–697. [Google Scholar] [CrossRef]
- Chen, S.N.; Shang, Y.; Wang, Y.; Schnabel, G.; Lin, Y.; Yin, L.F.; Luo, C.X. Sensitivity of Monilinia fructicola from peach farms in China to four fungicides and characterization of isolates resistant to carbendazim and azoxystrobin. Plant Dis. 2014, 98, 1555–1560. [Google Scholar] [CrossRef]
- Fan, F.; Li, N.; Li, G.Q.; Luo, C.X. Occurrence of fungicide resistance in Botrytis cinerea from greenhouse tomato in Hubei province, China. Plant Dis. 2016, 100, 2414–2421. [Google Scholar] [CrossRef]
- Fan, F.; Hamada, M.S.; Li, N.; Li, G.Q.; Luo, C.X. Multiple fungicide resistance in Botrytis cinerea from greenhouse strawberries in Hubei province, China. Plant Dis. 2017, 101, 601–606. [Google Scholar] [CrossRef]
- Sun, H.Y.; Wang, H.C.; Chen, Y.; Li, H.X.; Chen, C.J.; Zhou, M.G. Multiple resistance of Botrytis cinerea from vegetable crops to carbendazim, diethofencarb, procymidone, and pyrimethanil in China. Plant Dis. 2010, 94, 551–556. [Google Scholar] [CrossRef]
- Walker, A.S.; Micoud, A.; Remuson, F.; Grosman, J.; Gredt, M.; Leroux, P. French vineyards provide information that opens ways for effective resistance management of Botrytis cinerea (grey mould). Pest Manage. Sci. 2013, 69, 667–678. [Google Scholar] [CrossRef]
- He, L.M.; Cui, K.D.; Li, T.T.; Song, Y.F.; Liu, N.; Mu, W.; Liu, F. Evolution of the resistance of Botrytis cinerea to carbendazim and the current efficacy of carbendazim against gray mold after long-term discontinuation. Plant Dis. 2020, 104, 1647–1653. [Google Scholar] [CrossRef]
- Yang, F.; Abdelnabby, H.; Xiao, Y.N. Novel point mutations in beta-tubulin gene for carbendazim resistance maintaining nematode pathogenicity of Paecilomyces lilacinus. Eur. J. Plant Pathol. 2015, 143, 57–68. [Google Scholar] [CrossRef][Green Version]
- Zhao, Z.T.; Liu, H.Q.; Luo, Y.P.; Zhou, S.Y.; An, L.; Wang, C.F.; Jin, Q.J.; Zhou, M.G.; Xu, J.R. Molecular evolution and functional divergence of tubulin superfamily in the fungal tree of life. Sci. Rep. 2014, 4, 6746. [Google Scholar] [CrossRef]
- Oakley, B.R. Tubulins in Aspergillus nidulans. Fungal Genet. Biol. 2004, 41, 420–427. [Google Scholar] [CrossRef]
- Maymon, M.; Zveibil, A.; Pivonia, S.; Minz, D.; Freeman, S. Identification and characterization of benomyl-resistant and -sensitive populations of Colletotrichum gloeosporioides from statice (Limonium spp.). Phytopathology 2006, 96, 542–548. [Google Scholar] [CrossRef]
- Nakaune, R.; Nakano, M. Benornyl resistance of Colletotrichum acutatum is caused by enhanced expression of beta-tubulin 1 gene regulated by putative leucine zipper protein CaBEN1. Fungal Genet. Biol. 2007, 44, 1324–1335. [Google Scholar] [CrossRef]
- Zhou, Y.; Zhu, Y.; Li, Y.; Duan, Y.; Zhang, R.; Zhou, M. Beta 1 Tubulin rather than Beta 2 Tubulin is the preferred binding target for carbendazim in Fusarium graminearum. Phytopathology 2016, 106, 978–985. [Google Scholar] [CrossRef]
- Qiu, J.B.; Huang, T.T.; Xu, J.Q.; Bi, C.W.; Chen, C.J.; Zhou, M.G. Beta-Tubulins in Gibberella zeae: Their characterization and contribution to carbendazim resistance. Pest Manage. Sci. 2012, 68, 1191–1198. [Google Scholar] [CrossRef]
- May, G.S.; Tsang, M.L.S.; Smith, H.; Fidel, S.; Morris, N.R. Aspergillus nidulans β-tubulin genes are unusually divergent. Gene 1987, 55, 231–243. [Google Scholar] [CrossRef]
- Panaccione, D.G.; Hanau, R.M. Characterization of two divergent β-tubulin genes from Colletotrichum graminicola. Gene 1990, 86, 163–170. [Google Scholar] [CrossRef]
- Fujimura, M.; Kamakura, T.; Inoue, H.; Inoue, S.; Yamaguchi, I. Sensitivity of Neurospora crassa to benzimidazoles and N-phenylcarbamates: Effect of amino acid substitutions at position 198 in β-tubulin. Pestic. Biochem. Physiol. 1992, 44, 165–173. [Google Scholar] [CrossRef]
- Sevastos, A.; Markoglou, A.; Labrou, N.E.; Flouri, F.; Malandrakis, A. Molecular characterization, fitness and mycotoxin production of Fusarium graminearum laboratory strains resistant to benzimidazoles. Pestic. Biochem. Physiol. 2016, 128, 1–9. [Google Scholar] [CrossRef]

| Source x | Number of Isolates | Resistant Isolates | Sensitive Isolates | |||
|---|---|---|---|---|---|---|
| Number (%) y | EC50 (μg/mL) | Resistance Factor z | EC50 (μg/mL) | Mean ± SEM | ||
| Gaoyou | 53 | 0 | - | - | 0.143–1.269 | 0.671 ± 0.065 |
| Jurong | 28 | 2 (7.14%) | >500 | >814 | 0.208–1.231 | 0.668 ± 0.061 |
| Nanjing | 10 | 0 | - | - | 0.291–1.361 | 0.805 ± 0.169 |
| Taizhou | 46 | 0 | - | - | 0.108–1.320 | 0.607 ± 0.081 |
| Xinhua | 53 | 3 (5.66%) | >500 | >814 | 0.317–1.217 | 0.637 ± 0.042 |
| Xuyi | 35 | 2 (5.71%) | >500 | >814 | 0.128–1.324 | 0.657 ± 0.076 |
| Yizheng | 16 | 1 (6.25%) | >500 | >814 | 0.299–0.786 | 0.587 ± 0.077 |
| YZ Guanglin | 30 | 3 (10.00%) | 57.6~ > 500 | 94~>814 | 0.155–1.378 | 0.774 ± 0.122 |
| YZ Hanjiang | 21 | 1 (4.76%) | >500 | >814 | 0.278–0.983 | 0.703 ± 0.061 |
| Zhenjiang | 29 | 2 (6.90%) | >500 | >814 | 0.355–1.360 | 0.637 ± 0.070 |
| Total | 321 | 14 (4.36%) | 57.6~ > 500 | 94~>814 | 0.108–1.378 | 0.663 ± 0.031 |
| Isolate | Phenotype x | EC50 (μg/mL) y | MIC(μg/mL) z | ||
|---|---|---|---|---|---|
| T0 | T5 | T0 | T5 | ||
| GL11 | Carbendazim-R | 57.6 | 68.1 | >500 | >500 |
| GL12b | Carbendazim-R | 133.3 | 114.9 | >500 | >500 |
| Other isolates w | Carbendazim-R | >500 | >500 | >500 | >500 |
| Type of Mutation | Isolate | Mechanism | Change in Uvβ1Tub |
|---|---|---|---|
| Point mutation | GL11 | V91G | T to G |
| ZJ7 | A411D | C to A | |
| Non-sense mutation | GL12b | Q291 to stop | C to T |
| JR12 | W21 to stop | G to A | |
| Codon mutation | JR11 | codon 408–412 deletion | 15 bp deletion |
| YD8 | S221 deletion | 3 bp deletion | |
| Frameshift mutation | GL23 | frameshift | 7 bp deletion |
| HA17 | frameshift | 2 bp deletion | |
| XH5a | frameshift | 1 bp deletion | |
| XH43b | frameshift | 2 bp deletion | |
| YZ11 | frameshift | 2 bp deletion |
Publisher’s Note: MDPI stays neutral with regard to jurisdictional claims in published maps and institutional affiliations. |
© 2022 by the authors. Licensee MDPI, Basel, Switzerland. This article is an open access article distributed under the terms and conditions of the Creative Commons Attribution (CC BY) license (https://creativecommons.org/licenses/by/4.0/).
Share and Cite
Song, J.; Wang, Z.; Wang, Y.; Zhang, S.; Lei, T.; Liang, Y.; Dai, Q.; Huo, Z.; Xu, K.; Chen, S. Prevalence of Carbendazin Resistance in Field Populations of the Rice False Smut Pathogen Ustilaginoidea virens from Jiangsu, China, Molecular Mechanisms, and Fitness Stability. J. Fungi 2022, 8, 1311. https://doi.org/10.3390/jof8121311
Song J, Wang Z, Wang Y, Zhang S, Lei T, Liang Y, Dai Q, Huo Z, Xu K, Chen S. Prevalence of Carbendazin Resistance in Field Populations of the Rice False Smut Pathogen Ustilaginoidea virens from Jiangsu, China, Molecular Mechanisms, and Fitness Stability. Journal of Fungi. 2022; 8(12):1311. https://doi.org/10.3390/jof8121311
Chicago/Turabian StyleSong, Jiehui, Zhiying Wang, Yan Wang, Sijie Zhang, Tengyu Lei, You Liang, Qigen Dai, Zhongyang Huo, Ke Xu, and Shuning Chen. 2022. "Prevalence of Carbendazin Resistance in Field Populations of the Rice False Smut Pathogen Ustilaginoidea virens from Jiangsu, China, Molecular Mechanisms, and Fitness Stability" Journal of Fungi 8, no. 12: 1311. https://doi.org/10.3390/jof8121311
APA StyleSong, J., Wang, Z., Wang, Y., Zhang, S., Lei, T., Liang, Y., Dai, Q., Huo, Z., Xu, K., & Chen, S. (2022). Prevalence of Carbendazin Resistance in Field Populations of the Rice False Smut Pathogen Ustilaginoidea virens from Jiangsu, China, Molecular Mechanisms, and Fitness Stability. Journal of Fungi, 8(12), 1311. https://doi.org/10.3390/jof8121311








